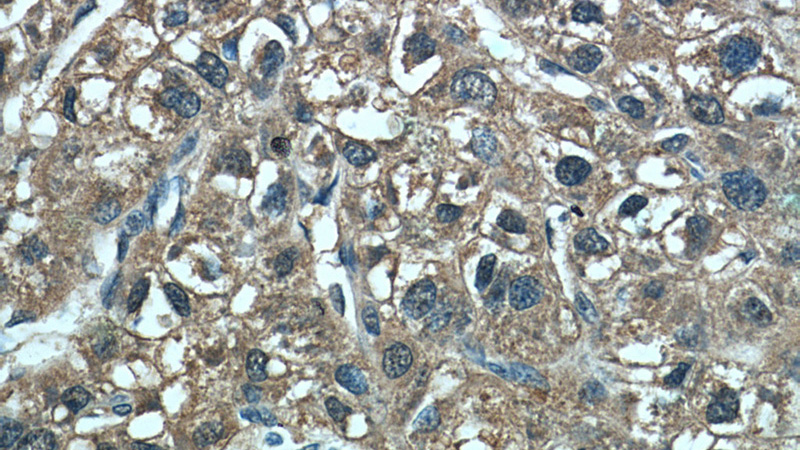
Immunohistochemistry of paraffin-embedded human liver cancer tissue slide using Catalog No:109917(DHFR Antibody) at dilution of 1:50 (under 40x lens)

-
Product Name
DHFR antibody
- Documents
-
Description
DHFR Rabbit Polyclonal antibody. Positive IHC detected in human liver cancer tissue, human breast cancer tissue. Positive IF detected in HeLa cells. Positive WB detected in K-562 cells, HeLa cells, Jurkat cells, Raji cells. Positive IP detected in Raji cells. Observed molecular weight by Western-blot: 21 kDa
-
Tested applications
ELISA, WB, IHC, IP, IF
-
Species reactivity
Human,Mouse,Rat; other species not tested.
-
Alternative names
DHFR antibody; DHFRP1 antibody; dihydrofolate reductase antibody
- Immunogen
-
Isotype
Rabbit IgG
-
Preparation
This antibody was obtained by immunization of DHFR recombinant protein (Accession Number: NM_000791). Purification method: Antigen affinity purified.
-
Clonality
Polyclonal
-
Formulation
PBS with 0.02% sodium azide and 50% glycerol pH 7.3.
-
Storage instructions
Store at -20℃. DO NOT ALIQUOT
-
Applications
Recommended Dilution:
WB: 1:200-1:2000
IP: 1:200-1:2000
IHC: 1:20-1:200
IF: 1:20-1:200
-
Validations

K-562 cells were subjected to SDS PAGE followed by western blot with Catalog No:109917(DHFR antibody) at dilution of 1:500

IP Result of anti-DHFR (IP:Catalog No:109917, 3ug; Detection:Catalog No:109917 1:500) with Raji cells lysate 2000ug.

Immunohistochemistry of paraffin-embedded human liver cancer tissue slide using Catalog No:109917(DHFR Antibody) at dilution of 1:50 (under 10x lens)
Immunohistochemistry of paraffin-embedded human liver cancer tissue slide using Catalog No:109917(DHFR Antibody) at dilution of 1:50 (under 40x lens)

Immunofluorescent analysis of HeLa cells using Catalog No:109917(DHFR Antibody) at dilution of 1:50 and Alexa Fluor 488-congugated AffiniPure Goat Anti-Rabbit IgG(H+L)
-
Background
DHFR(dihydrofolate reductase) catalyzes the subsequent NADPH-dependent reduction of the H2folate produced by TS to regenerate the tetrahydrofolate (H4folate) necessary for continued dTMP synthesis and transfer of 1-carbon units(PMID:3461439). It belongs to the dihydrofolate reductase family and can exsit as a homodimer(PMID:2248959). DHFR is widely expressed in fetal and adult human brain and whole blood,expression is higher in adult brain than fetal brain (PMID:21310276).
-
References
- Banka S, Blom HJ, Walter J. Identification and characterization of an inborn error of metabolism caused by dihydrofolate reductase deficiency. American journal of human genetics. 88(2):216-25. 2011.
- Yan KH, Lee LM, Hsieh MC. Aspirin antagonizes the cytotoxic effect of methotrexate in lung cancer cells. Oncology reports. 30(3):1497-505. 2013.
Related Products / Services
Please note: All products are "FOR RESEARCH USE ONLY AND ARE NOT INTENDED FOR DIAGNOSTIC OR THERAPEUTIC USE"
